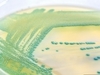

-
 专家教你如何正确选择保健品
2011-03-09
专家教你如何正确选择保健品
2011-03-09
-
 三类保健产品多为虚假产品
2011-03-09
三类保健产品多为虚假产品
2011-03-09
-
 药食两用保健品让你远离妇科病
2011-03-09
药食两用保健品让你远离妇科病
2011-03-09
-
 30岁女性常喝酸奶塑造挺拔身材
2011-03-09
30岁女性常喝酸奶塑造挺拔身材
2011-03-09
-
养颜保健 让女人越活越年轻
养颜保健 让女人越活越年轻
从古至今,女人最为害怕的就是衰老,当自己发现脸上第一条皱纹的时候,那种惴惴不安的感觉对每一个女人都是刻骨铭心的。衰老固然不可避免,但是总可以让衰老的脚步放
2011-03-09 -
 不能忽略女人滋阴补血良品
2011-03-09
不能忽略女人滋阴补血良品
2011-03-09
-
 滥用保健品 小心得“女人病”
滥用保健品 小心得“女人病”
随着人们健康意识的提高,保健品市场也日益火爆,而女性保健品又占了保健品市场的很大一部分,所以各地女性保健品的厂家都盯紧了女性市场这块肥肉,争得不可开交
2011-03-09 -
 胶原蛋白或致乳腺增生
胶原蛋白或致乳腺增生
面对琳琅满目的保健品,女性如何挑选?业内人士提醒,看似有效的女性保健品中,常违规添加激素成分。挑选保健品时,最好选择戴有“蓝帽子”标志的,质量更有保证。
2011-02-21 -
 更年期女性如何选择保健品?
更年期女性如何选择保健品?
身为女性,你了解自己的身体吗?从青春期到更年期,你该如何珍爱自己的身体?当一个又一个的问题摆在你的面前时,你有否有些茫然与不安?平安健康网带你走进女性身体的秘密花园,以最贴心的指导,最实用的资讯让你了解各个生理时期所面临的健康问题。
2010-07-28 -
 谁是女人的补血佳品
谁是女人的补血佳品
市场上补血的保健品真是琳琅满目啊,可真想买的时候是不是不知道该买哪种呢?
2010-06-20 -
 电脑族女性喝哪些保健饮品
电脑族女性喝哪些保健饮品
张丽萍小姐,今年25岁,在我市某房地产公司做了两年办公室文秘工作。据她介绍,她刚到公司的时候,同事们都很羡慕她有着光滑、白净的皮肤,再加上人长得很漂亮,在整个公司都很出众
2010-06-20 -
 卫生巾吸收力强未必好
卫生巾吸收力强未必好
对于卫生巾的选择,世界卫生组织妇女健康研究和培训合作中心主任丁辉说,经期用品的清洁卫生特别重要。
2010-05-30 -
 影响女性健康的几种女性用品
影响女性健康的几种女性用品
怎么呵护私密花园的健康?下半身的健康,攸关个人生活品质与亲密关系。针对女性下半身的时尚设计、生理用品不断推陈出新,对阴部健康是有加分还是减分效果?
2010-05-30 -
 女性用卫生巾应避开的误区
女性用卫生巾应避开的误区
卫生巾功能选对路,当然可以让我们享受到更多的舒适和呵护。但是不要忘了,卫生巾使用上一系列司空见惯的坏习惯却会让我们在最脆弱的生理周期吃上妇科炎症的苦头。
2010-05-30 -
青春补品可能引起乳癌你知道多少?
滥用含雌激素类保健品,可能导致乳腺癌。前段时间在上海召开的2006年中国乳腺内分泌治疗高峰论坛上,中华医学会肿瘤学会副主任委员、上海市乳腺癌临床医疗中心首席专家沈镇宙呼吁:都市女性不要滥用保健品,因为服用含有雌激素的保健品可能导致乳腺癌的发生。在临床中发现,不少乳腺癌患者在发病之前都曾经服用过一些号称“永葆青春”保健品。
2009-12-15
- 南宁hpv医院靠不靠谱,南宁hpv的好医院
- 南宁hpv医院好不好,南宁hpv专业医院
- 速览!南宁看hpv什么医院口碑比较好-南宁看hpv专项医院
- 揭晓:南宁治hpv的医院哪些好-新鲜出炉-南宁诊治hpv靠谱的医院
- 南宁查hpv一共多少价格,南宁查hpv的好医院
- 南宁查hpv大约花费多少钱,南宁查hpv比较正规的医院
- 南宁查hpv总共多少钱,南宁查hpv的有效医院
- 南宁治梅毒需要花费多少钱,南宁治梅毒效果比较好的专科医院
- 揭晓:南宁治梅毒好多钱-新鲜出炉-专业发布-南宁治梅毒靠谱点的医院
- 要闻榜单:昆明治疗hpv哪个医院比较好-医院排名-昆明治疗hpv好点的专科医院
- 昆明hpv医院哪家强,昆明hpv较好医院
- 昆明治hpv什么价位,昆明治hpv专科定点医院
- 昆明治hpv什么费用,昆明治hpv的好口碑医院
- 医疗汇总:昆明治hpv多少价钱-昆明治hpv的有效医院
- 昆明看梅毒什么医院比较可靠-排名名单-昆明看梅毒有效的专科医院排行榜
- 实时聚焦:昆明治梅毒哪里的医院比较好,昆明治梅毒比较专业的医院
- 昆明梅毒专科医院怎么样,昆明梅毒正规医院
- 背上的脂肪瘤需要切除吗
- 脂肪瘤会越摸越大吗
- 脂肪瘤都是良性吗
- 头皮下脂肪瘤有什么危害
- 脂肪瘤会变成脂肪肉瘤吗
- 血管脂肪瘤会恶变吗
- 良性纵隔肿瘤的症状
- 放疗后肋骨疼是怎么回事
- 色素痣是肿瘤吗
- 肾上腺脂肪瘤要手术吗
- 眼眶放疗后遗症有哪些
- 皮下囊肿和脂肪瘤区别
- 血管瘤严重了会是什么结果
- 阴道炎可以吃生蚝吗
- 24岁乳腺增生正常吗
- 孕妇有宫颈糜烂对胎儿有影响吗
- 月经推迟一周b超能看到孕囊吗
- 硝呋太尔制霉素软胶囊可以治疗宫颈炎吗
- 尖锐湿疣潜伏期多长时间能查出来
- hpv是什么病有什么表现
- 尖锐湿疣形成原因
- 淋病治好后还会得吗
- hpv52型阳性会有什么症状吗
- 山西哪些医院看尖锐湿疣专业-山西比较好的尖锐湿疣医院前五排行?
- 热点公布!山西排名前五的尖锐湿疣医院-山西尖锐湿疣医院排行榜?
- 专业山西梅毒医院排行榜-山西哪所医院看梅毒好一些?
- 山西哪家医院治疗hpv最好-山西排行前五的hpv医院?
- 山西那个医院治疗hpv口碑好-山西排名前三的hpv医院?
- 太原正规生殖疱疹医院「排行榜」太原那个医院看生殖疱疹最好?
- 太原专门看hpv的医院是哪个-太原比较好的hpv医院五佳排行?
- 最新公开!山西治疗梅毒好一些的医院排行榜-山西梅毒医院排名?
- 治疗尖锐湿疣到山西那个医院好-山西五佳看尖锐湿疣的医院排名榜单
- 太原那家医院看尖锐湿疣最好-太原市尖锐湿疣专科医院五大排行
- 看hpv到山西那家医院最好-山西五大hpv科医院排行榜单?
- 山西那个生殖疱疹医院好-山西生殖疱疹医院前五排名?
- 山西哪家医院治疗hpv口碑最好-山西排行前五的hpv医院?
- 山西看hpv评价好的医院公开-山西hpv医院前五排名?
- 治疗hpv到山西那家医院比较好-山西五大看hpv的医院排行
- 山西哪一个医院看hpv最专业-山西五佳hpv医院排行榜?
- 山西淋病医院那一家好-山西淋病科医院前三排名榜?
- 山西专业看尖锐湿疣的医院前三名-山西那家尖锐湿疣医院好?
- 武汉膀胱结石治疗复杂结石的医院
- 南昌看原发性早泄排名前十的医院
- 医院科室网站地图
- 医院库网站地图
- 医生库网站地图
- 就医助手网站地图
- 北京茗视光眼科
- 郑州圣玛妇产医院
- 郑州康好医院
- 宁波博润白癜风专病门诊
- 陕西省老医协医院外阴白斑诊疗中心
- 北京家恩德运医院
- 长春三零六中医院
- 上海江城皮肤病医院
- 昆明曙光医院男科
- 南京市浦口人民医院
- 大连航天医院
- 重庆华肤皮肤病医院性病科
- 石家庄燕赵医院
- 沈阳六一儿童医院
- 滨州华海白癜风医院
- 北京裕和中西医结合康复医院
- 乌鲁木齐药业附属医院
- 合肥天佑白癜风医院
- 南京太乙堂中医医院
- 连云港建国医院
- 北京华坛中西医结合医院
- 南京天佑儿童医院
- 咸阳肿瘤医院
- 长沙大医医院
- 石家庄远大白癜风医院
- 郑州医大生殖医院
- 深圳益尚白癜风
- 太原九州医院
- 南京圣贝中西医性病科
- 成都博润白癜风医院
- 重庆优眠精神心理专科
- 重庆临江门医院
- 黄石德亚泌尿专科
- 贵阳中医脑康儿童医院
- 北京京城皮肤医院
- 北京首大眼耳鼻喉医院
- 张家口朝聚眼科医院
- 长沙中科白癜风医院
- 南京华厦白癜风
- 重庆红楼医院
- 潍坊潍城经开医院
- 广州天使儿童医院
- 郑州西京白癜风医院
- 武汉阿波罗医院
- 沈阳中亚白癜风医院
- 长沙癫康医院
- 苏州东吴中西医结合医院妇科
- 南京太乙堂中医院
- 曲靖五洲妇产医院
- 上海江城皮肤病医院性病科
- 成都棕南医院
- 常州花园医院妇科
- 常州花园医院
- 重庆中德生殖医院
- 合肥华研白癜风医院
- 泰州鼓楼男科医院
- 昆明男健医院
- 杭州城东医院
- 郑州长江中医院
- 广州附医华南医院
- 云南九洲医院妇科
- 贵阳强直医院
- 西安远大白癜风专科医院
- 北京华医中西医结合皮肤病医院
- 重庆曙光男科医院
- 成都棕南医院精神科
- 上海江城牛皮癣医院
- 苏州瑞京白癜风门诊部
- 广州复大肿瘤医院
- 青岛市北银康医院
- 郑州痛风风湿病医院
- 南昌普瑞眼科医院
- 杭州华研白癜风病医院
- 福建三博福能脑科医院
- 苏州东吴中西医结合医院
- 无锡顾连医院
- 成都中科生殖医院
- 济南中医肝病医院
- 昆明艾维眼科医院
- 武汉天佑之星儿童医院
- 北京振国中西医结合肿瘤医院
- 四川省生殖健康研究中心附属生殖专科医院
- 成都三博东篱医院
- 南宁首大医院
- 上海华研医院
- 南京华肤皮肤病医院
- 郑州德馨医院
- 兰州仁和医院
- 辽宁癫康医院
- 苏州苏哈医院
- 苏州肤康皮肤病医院
- 武汉太医堂中医院
- 太原纺织职工医院
- 济南童康儿童医院
- 贵阳中医脑康医院
- 南京茀莱堡口腔医院
- 上海徐浦中医医院
- 济南天大白癜风医院
- 广州华康中医医院
- 上海江城白癜风医院
- 长沙华研白癜风医院
- 成都棕南医院私密整形中心
- 昆明博骨痛风风湿中西医结合医院
- 宁波海曙华仁皮肤白癜风专科
- 成都西部痛风风湿医院
- 西安仁爱白癜风医院
- 上海九龙医院精神心理科
- 四川中医肝病医院
- 成都蓉城中医白斑门诊部
- 东莞博润中医医院
- 成都西南儿童医院
- 郑州金水脑康中医院
- 西安莲湖中童儿童康复医院
- 郑州绿城儿童医院
- 黑龙江远东心脑血管医院
- 天津爱维医院
- 郑州新世纪医院
- 上海宏康医院
- 深圳肤康皮肤病专科门诊部
- 苏州国医堂医院
- 成都医科医院
- 杭州阿波罗医院
- 合肥中山医院
- 昆明杰西艾整形外科医院·私密整形中心
- 重庆军科整形美容医院·私密整形中心
- 兰州中研白癜风医院
- 武汉首义玛丽亚妇产医院
- 辽宁附一医院
- 郑州华夏中医白癜风医院
- 成都风湿医院
- 武汉华美整形外科医院·私密整形中心
- 成都美容整形医院·私密整形中心
- 南宁华美医疗美容医院·私密整形中心
- 郑州医大医院妇科
- 沈阳沈大医院男科
- 烟台半岛白癜风医院
- 兰州天伦生殖不孕症医院
- 南京痛十凤医院
- 上海虹桥医院白癜风专病
- 成都西部白癜风医院
- 沈阳沈大医院
- 广州强直葆髋骨科医院
- 沈阳沈大医院病毒科
- 上海仁树门诊部
- 北京瑶医医院
- 济南国医堂医院
- 合肥天使儿童医院
- 兰州中医白癜风医院
- 成都中医哮喘医院
- 贵阳六一儿童医院
- 上海普瑞眼科医院
- 哈尔滨强直风湿医院
- 成都性病医院
- 深圳腋秀腋臭研究院
- 潍坊鸢飞肛肠外科医院
- 广州复星禅诚医院
- 泰康同济(武汉)医院
- 南京泰康仙林鼓楼医院
- 北京京和堂中医医院
- 重庆天佑儿童医院
- 上海希玛瑞视眼科医院
- 南宁脑博仕医院
- 昆明联大医院
- 成都西南皮肤病医院
- 南宁九龙医院
- 西安莲湖生殖医院
- 兰州中西医医院
- 昆明五华云一儿童医院
- 哈尔滨大直门医院
- 青岛百姓中医院
- 杭州天目山医院儿科
- 西安胃泰消化病医院
- 黑龙江京科脑康医院
- 南京金陵中西医结合医院
- 北京人和中医院
- 成都赫尔森康复医院耳鼻喉科
- 合肥华安脑科医院
- 济南远大中医脑康医院
- 成都西南脑科医院
- 成都成华脑康心理医院
- 西宁北康医院
- 西安生殖医学医院不孕不育
- 广州中研白癜风医院
- 北京男科医院
- 河北中医肝病医院
- 济南中医风湿病医院
- 沈阳肿瘤医院
- 济南天使儿童医院
- 广州华康中医医院儿科
- 杭州武林医院
- 上海源锐门诊部
- 济南南郊医院
- 北京方舟医院
- 更多医疗资讯
- 天津阳光男科医院
- 安徽中医药附属医院
- 天津阿波罗医院
- 北京建都医院
- 沈阳省医妇科医院
- 乌鲁木齐新军都白癜风医院
- 北京航空总医院
- 天津和平九洲医院
- 北京天使儿童医院
- 湖州湖城泌尿专科
- 南宁长江医院
- 襄阳市第三人民医院
- 南昌博润银屑病专病门诊
- 北京嘉佩乐医院
- 天津阳光医院
- 长春航天生殖健康医院
- 漳州芗城博爱医院男科
- 杭州华研白癜风病医院
- 昆明首康医院
- 成都金牛真爱医院
- 南京邦德中医医院
- 北京国丹白癜风医院
- 菏泽博奥泌尿外科医院
- 长沙肤康皮肤病医院
- 武汉太医堂中医院
- 上海虹桥医院
- 石家庄普济医院牛皮癣科
- 吉林国健妇产医院
- 南通海江医院
- 石家庄蓝天中医院
- 武汉环亚中医白癜风医院
- 石家庄蓝天中医院男科
- 上海美申白癜风
- 上海虹桥医院癫痫专病
- 上海虹桥医院耳鼻喉科
- 沈阳肤康皮肤病医院
- 南京玛丽妇产医院
- 潍坊长安医院
- 合肥天使儿童医院
- 济南癫痫病医院
- 南阳白癜风医院
- 大连美琳达妇儿医院
- 上饶中山医院
- 合肥华夏白癜风医院
- 杭州甲康医院
- 重庆中研皮肤病白癜风医院
- 长春肤康医院
- 盐城德馨医院
- 北京中科白癜风
- 汕头中科白癜风门诊
- 陕西省老医协生殖医学医院男科
- 上海九龙医院
- 北京北城中医医院
- 广东药科大学附属第三医院手汗症
- 贵州白癜风皮肤病医院
- 广州科大中医医院妇科
- 南京华厦白癜风
- 北京华医中西医结合皮肤病医院
- 兰州中研医院
- 济南远大中医脑康医院
- 南宁九龙医院
- 台州五洲生殖医学医院
- 唐山中都白癜风医院
- 昆明白癜风皮肤病医院
- 广州长安医院不孕不育
- 天津南开滨江医院胃肠科
- 泸州丽人妇产医院
- 苏州吴州中西医结合医院耳鼻喉
- 昆明白癜风皮肤病专科医院
- 北京中科白癜风医院
- 上海虹桥医院尿道下裂
- 广州蕙心医院
- 广州天使儿童医院
- 广东药科大学附属第三医院癫痫病
- 廊坊友谊医院
- 上海华美医疗美容医院
- 沈阳祥芸医院
- 武汉天佑之星儿童医院
- 山西省商业供销职工医院
- 郑州华山不孕不育医院
- 郑州科大医院胎记科
- 南京维多利亚美容医院
- 郑州中科甲状腺医院
- 广州和谐医院神经内科
- 合肥协大皮肤病医院
- 常州花园医院妇科
- 杭州东方医院
- 云南九州医院
- 广州番禺区康华医院
- 沈阳京科医院
- 包头世纪泌尿专科医院
- 泰州东方医院
- 昆明三一一医院
- 廊坊友谊医院男科
- 苏州东吴中西医结合医院
- 海口椰城医院
- 上海禾新医院
- 惠州友禾医院
- 德州安德医院
- 唐山唐诚医院
- 宁波海曙天一医院
- 衡水英伦男仕医院
- 湖州爱山医院
- 昆明眼科医院
- 榆林博爱医院
- 福州福兴妇产医院
- 南昌市第十二医院
- 郑州华夏中医白癜风医院
- 成都锦一医院
- 广州长安医院妇科
- 滨州华海白癜风医院
- 襄阳紫荆妇产医院
- 上海虹桥医院白癜风专病
- 沈阳皇姑医院
- 黑龙江京科脑康医院
- 榆林博爱医院妇科
- 陕西远大男病专科医院
- 济南六一儿童医院
- 成都九龙医院
- 内蒙古世纪医院
- 石家庄男科医院
- 安徽华高生物
- 常德九龙医院
- 南京男健医院
- 保定京都皮肤病医院
- 太原肤康中医皮肤病医院
- 郴州建国医院
- 太原科大精神心理专科
- 武汉阿波罗医院男科
- 宁波江北复大医院
- 无锡虹桥医院
- 重庆东大肛肠医院
- 德阳玛丽妇产医院
- 北京国华中医医院
- 南京太乙堂中医院
- 杭州天目山医院
- 连云港建国医院
- 上海健桥医院白癜风科
- 北京紫荆医院
- 南京龙蟠结石医院
- 福州博爱中医院
- 南京痛十凤医院
- 上海优比
- 厦门优眠医学中心
- 昆明爱维艾夫医院
- 济南中医白癜风医院
- 哈尔滨维多利亚妇产医院
- 顺德医大医院
- 广州和谐医院性病科
- 长春博润皮肤病医院
- 南京泰康鼓楼仙林医院
- 北京四惠中医医院
- 烟台京城医院
- 上海虹桥医院胎记
- 常州花园医院
- 南宁曙光医院
- 福州博爱男科医院
- 安康亲子鉴定中心
- 广州健肤皮肤专科
- 临沂强仕泌尿医院
- 太原中山生殖医学医院
- 福州博爱中医院男科
- 绍兴柯桥柯华男科
- 大同曙光医院
- 成都玛丽亚天府妇产儿童医院
- 哈尔滨冰江男科医院
- 运城泌尿医院
- 台州路桥南方妇产医院
- 苏州瑞金
- 哈尔滨济康医院
- 重庆宝莱生殖健康医院
- 南昌首大医院
- 嘉兴博爱男科
- 秦皇岛曙光医院
- 合肥银康银屑病医院
- 南昌白癜风医院
- 黄石德亚泌尿专科
- 贵阳皮肤病专科医院
- 杭州华实医院
- 重庆中肾医院
- 合肥北大白癜风医院
- 广东药科大学附属第三医院肿瘤二科
- 成都九龙医院妇科
- 兰州友好银屑病医院
- 南宁城和医院
- 兰州中研白癜风医院
- 福州博润白癜风
- 郑州建功银屑病医院
- 杭州红房子妇产医院
- 郑州西京白癜风医院
- 南宁福康医院
- 三亚博大男科
- 东莞国岸医院
- 南宁城和医院不孕不育科
- 杭州华实医院男科
- 运城市现代妇科医院
- 乌鲁木齐南湖医院男科
- 河南郑州西京白癜风医院
- 义乌微创外科医院
- 南宁西京白癜风专科医院
- 徐州国信康医院
- 义乌微创医院
- 太原纺织职工医院
- 广东泰成医院
- 北京卫人中医院
- 东莞博润中医医院
- 郑州新世纪医院
- 郑州首大医院
- 成都银康银屑病医院
- 贵州白癜风皮肤病医院银屑病科室
- 威海幸福中医医院
- 烟台半岛白癜风医院
- 苏州银康银屑病专病门诊
- 张家口曙光医院
- 北京市房山区华禹护理院
- 南京家和医院妇科
- 西安脑康心理康复医院
- 山西黄河医院
- 南昌丰益肛肠医院?
- 上海中佑肛肠
- 上海健桥医院白癜风专科
- 江西九三医院性病科
- 贵阳强直医院
- 广州建国医院男科
- 武汉京都结石医院
- 保定京都皮肤病医院性病科
- 成都润禾皮肤病专科医院
- 昆明皮肤病专科医院性病科
- 贵阳正宇铁路医院
- 济宁博仕医院
- 青岛海博医院
- 临沂现代医院
- 贵阳康泰医院男科
- 成都风湿医院
- 郑州痛风风湿病医院
- 辽宁癫康医院
- 甘肃博杰泌尿性疾病研究所门诊部
- 哈尔滨协佳医院男科
- 宁波海曙华美妇女专科医院
- 郑州国医堂医院
- 徐州心理卫生服务站
- 北京朝阳门中西医结合医院
- 合肥军海医院性病科
- 苍南苍健泌尿专科
- 广州建国医院妇科
- 广州建国男科医院(新增)
- 郑州市二七医院
- 嘉兴嘉慈中西医结合医院
- 沭阳现代医院
- 南京丁义山专科医院
- 南京德牙联合口腔医院
- 广州建国医院
- 南京五洲医院
- 昆山紫荆医院
- 成都润禾皮肤病专科医院性病科(增投)
- 南昌附大医院
- 西安兴成生长发育中心
- 合肥京石结石医院
- 北京丰台广济中西医结合医院
- 北京丰台广济医院性病
- 北京京和堂中医医院
- 宁波海曙友好医院
- 云南中西医结合医院精神科
- 温岭恒山男科
- 南京家和医院性病
- 昆明皮肤性病专科医院
- 保定京都皮肤性病科医院
- 宁波国康医院耳鼻喉科
- 暨南大学崇爱医院
- 黑龙江医健老年医院
- 上海光泽医院
- 杭州天目山医院结石科
- 郑州二七医院
- 贵阳康泰医院
- 市北百姓中医医院
- 昆明台俪妇产医院 "
- 深圳君鑫门诊部白癜风专科 " "
- 郑州医大医院妇科 " "
- 台州浙康医院 "
- 安徽合肥华研白癜风医院
- 保定华仁白癜风医院
- 保定京济医院
- 北京昌平政和中医医院
- 北京德胜门中医院精神科
- 北京德胜门中医院皮肤科
- 北京德胜门中医院胃肠科
- 北京东大肛肠医院
- 北京方舟皮肤病医院
- 北京丰台广济医院
- 北京丰台人和中医医院
- 北京国丹医院
- 北京华科胃肠医院
- 北京华科中西医结合医院
- 北京首大眼耳鼻喉医院
- 北京希玛林顺潮眼科医院
- 沧州华诺医院
- 沧州九龙医院
- 成都军盛癫痫医院
- 成都神康癫痫病医院
- 成都神康癫痫医院
- 成都市博润白癜风医院(新增)
- 成都市曙光医院(资讯)
- 成都曙光男科医院
- 成都曙光医院
- 成都曙光医院男科
- 成都西部白癜风医院
- 成都西部白癜风医院(新增)
- 成都中医哮喘病医院
- 成都棕南妇科医院
- 成都棕南私密整形中心
- 成都棕南医院精神卫生中心
- 成都棕南医院乳腺科
- 成都棕南医院腺肌症
- 大连北医八医院
- 大连北医八医院性病科
- 东莞莞医医院
- 东阳南健男科
- 福建泉州中科白癜风医院
- 甘肃兰州中医白癜风医院(新增)
- 赣州中研白癜风研究院
- 广东省中研白癜风研究院
- 广州好运医院外阴白斑科
- 广州和谐医院
- 广州恒健医院
- 广州脑博仕医院
- 广州新世纪白癜风防治研究院
- 广州新世纪白癜风医院
- 广州新世纪医院银屑病专科
- 广州长安医院
- 广州中研白癜风(新增)
- 贵港强盾医院
- 贵阳常春藤医院(11.25暂停)
- 贵阳中医脑康医院
- 贵州贵阳中医脑康医院
- 海南男科疾病治疗中心
- 邯郸男健医院
- 杭州广仁医院
- 杭州仁德妇科医院
- 合肥华研白癜风医院
- 合肥长淮中医医院精神科
- 河北石家庄远大白癜风医院(新增)
- 黑龙江盛京白癜风医院
- 黑龙江盛京皮肤病医院
- 黑龙江中亚癫痫病医院
- 湖南长沙中研白癜风医院
- 惠州友好医院
- 济南艾玛妇产医院
- 济南白癜风医院
- 济南博润牛皮癣医院
- 济南博润银屑病医院
- 济南耳鼻喉医院
- 济南复大肿瘤医院
- 济南甲康医院
- 济南天大白癜风医院
- 金华盛兴医院
- 昆明复美白癜风医院
- 昆明泌尿生殖专科医院
- 兰州脑康中西医医院
- 兰州中西医结合医院
- 兰州中医白癜风医院
- 临沂远大白癜风医院
- 吕梁黄河医院
- 牡丹江现代泌尿专科医院
- 南昌博大耳鼻咽喉医院
- 南昌博士医院
- 南昌国丹白癜风医院
- 南昌市第五医院
- 南京华肤医院
- 南京华厦银屑病门诊部
- 南京甲康医院
- 南京京科医院不孕不育
- 南京京科医院男科
- 南京脑康中医医院
- 南京脑康中医院
- 南京圣贝中西医医院
- 南京天佑儿童医院
- 南京长江医院
- 南宁肤康医院
- 南宁脑博士医院
- 南宁首大医院
- 南宁西京白癜风医院
- 南通复大皮肤病专科门诊部
- 宁波海曙欧亚医院
- 宁波海曙普仁医院男科(新增)
- 宁波华仁白癜风
- 宁波华仁皮肤白癜风专科
- 青岛市北银康医院
- 泉州中科白癜风医院
- 山东济南白癜风医院
- 山东省济南哮喘病医院
- 山西太原白癜风医院
- 山西太原银康银屑病
- 上海百佳妇产医院
- 上海健桥医院
- 上海江城白癜风医院
- 上海江城牛皮癣医院
- 上海江城皮肤病医院
- 上海江城性病医院
- 上海强直医院
- 上海新科脑康医院
- 上海中大肿瘤医院
- 深圳肤康皮肤病专科门诊部
- 深圳益尚白癜风专科
- 深圳优眠临床心理专科
- 沈阳六一儿童医院
- 沈阳沈大妇科医院
- 沈阳沈大男科医院
- 沈阳沈大性病医院
- 沈阳沈大医院
- 沈阳沈大医院外阴白斑科
- 沈阳市国医甲状腺医院
- 沈阳中科白癜风医院
- 沈阳中亚白癜风医院(新增)
- 沈阳中亚白癜风中医医院
- 石家庄远大白癜风医院
- 苏州肤康皮肤病医院
- 苏州肤康皮肤病医院白癜风专科
- 苏州瑞金白癜风门诊部
- 苏州吴州男科医院
- 苏州吴州中西医结合医院
- 苏州吴州中西医结合医院男科
- 台州京科皮肤病门诊
- 太原癫痫病医院
- 太原九龙泌尿医院
- 太原九州皮肤病医院
- 太原天使儿童医院
- 天津红桥中都白癜风医院
- 天津金桥医院
- 潍坊东方银屑病研究院
- 潍坊京都白癜风医院
- 渭南益健医院男科
- 温州东瓯医院
- 温州建国男科医院
- 温州建国医院儿科
- 温州建国医院男性专科
- 温州中研白癜风专科
- 乌鲁木齐华夏医院
- 乌鲁木齐南湖医院
- 无锡开源白癜风
- 无锡市滨湖区皮肤病性病门诊部
- 武汉阿波罗男科医院
- 武汉阿波罗医院
- 武汉广爱医院疼痛科
- 武汉甲康医院
- 西安甲康医院
- 西安莲湖肤康中医医院
- 西安仁爱白癜风(新增)
- 西安仁爱白癜风医院
- 西安仁爱银屑病医院
- 西安现代妇产医院
- 西安远大白癜风医院
- 西安远大中医皮肤病医院(新增)
- 西安中际癫痫病医院
- 西宁青北皮肤病医院
- 咸阳九龙医院
- 湘潭阿波罗医院
- 湘潭龙华医院
- 邢台广慈医院
- 扬州仁爱医院
- 云南中西医结合医院
- 湛江男健男科
- 长春中西医结合医院
- 长沙华研皮肤病医院(11.19暂停)
- 长沙新湘医院
- 长沙中科白癜风医院
- 长沙中科皮肤病医院
- 长沙中研白癜风医院
- 长治泌尿专业医院
- 郑州军海脑病医院
- 郑州康好医院
- 郑州天伦医院
- 郑州医大生殖医院
- 郑州医大医院男科
- 郑州中原科大医院外阴白斑科
- 重庆迪邦白癜风医院
- 重庆迪邦皮肤病医院
- 重庆迪邦皮肤病医院白癜风科
- 重庆华肤皮肤病医院
- 重庆华肤皮肤病医院皮肤科
- 重庆惠民癫康医院
- 重庆渝都生殖医院
- 淄博中大泌尿外科医院
- 重庆黄泥磅外阴白斑医院
- 宁波博润白癜风
- 郑州博肤胎记医院
- 成都博肤胎记医院
- 昆明皮肤病专科医院
- 山西惠民医院
- 重庆曙光男科(新增)
- 乌鲁木齐友善医院
- 四川华西肝病研究所附属门诊部
- 大同幸福男科医院
- 南昌博大甲状腺医院
- 义乌康源男科(新增)
- 深圳鹏程医院
- 武汉中诺口腔医院
- 天津中诺种植牙医院
- 合肥白领安琪儿妇产医院
- 重庆仁爱医院
- 成都青羊蓉城中医白斑门诊部
- 盐城东方妇产医院
- 贵阳中医甲状腺医院
- 北京十里河医院
- 重庆曙光男科医院
- 河北蕴育医院
- 泉州丰泽鲤泉医院
- 邯郸燕赵中医医院
- 西安莲湖兴成医院外阴白斑
- 成都玛丽亚妇产医院
- 合肥喜得儿生殖健康医院男科
- 天津坤如玛丽妇产医院
- 广州益寿医院
- 常州康瑞世纪医院
- 天津中幸口腔医院
- 无锡博仁医院
- 广州皇家丽肿瘤医院
- 大庆中都泌尿医院
- 岳阳世纪医院
- 广州粤海医院
- 山东东方医院
- 上海徐浦中医医院
- 成都西部甲状腺医院
- 济南童康儿童医院
- 天津市中幸口腔医院
- 临汾博爱生殖医学医院
- 西安康宁心理医院
- 临沂首大生殖医院
- 唐山华北妇产医院
- 广州中医药大学金沙洲医院
- 广州百信医院
- 邵阳市大祥区人民医院
- 安阳蓝天中医医院
- 长沙和谐医院
- 重庆黄泥磅医院口腔黏膜
- 唐山站前医院
- 珠海阳光医院
- 无锡坤如玛丽医院
- 运城玛丽妇科医院
- 南京肤康皮肤病专病
- 甘肃玛丽亚妇产医院
- 贵州省红十字会医院
- 武汉广爱精神医院
- 苏州圣爱妇产医院
- 佛山市顺德和平外科医院
- 太原纺织医院
- 上海虹桥减重医院
- 上海虹桥医院甲状腺
- 河南誉美肾病医院
- 广州和谐医院精神科
- 西安仁爱胎记医院
- 武汉北大白癜风医院
- 北京联科中医肾病医院
- 泉州鲤泉医院
- 上海虹桥医院面瘫
- 山东东方男科医院
- 重庆送子鸟医院
- 成都天大不孕不育医院
- 上海都市医院外阴白斑
- 西安莲湖生殖医院
- 常熟中山男科医院
- 濮阳东方男科
- 湖北省地质职工医院
- 绍兴康华门诊部
- 太原纺织医院外阴白斑
- 南宁华夏医院
- 昆明曙光医院
- 黑龙江远东心脑血管医院
- 兰州陇大医院
- 盐城华研白癜风专科
- 北京刘家窑中医医院
- 湖北省地质医院
- 贵阳仁爱医院
- 洛阳白马妇产医院
- 北京和平中西医结合医院
- 宁夏西京妇产医院
- 南京肛泰中医医院
- 义乌康源综合门诊部
- 哈尔滨神安医院
- 义乌建国医院
- 天津市中诺口腔医院
- 娄底阳光医院
- 常州康瑞世纪医院妇科
- 贵阳脑癫医院
- 福州国德医院
- 昆明曙光医院男科(新增)
- 昆明中研甲状腺医院
- 西安莲湖生殖医院男科
- 西安莲湖生殖医院妇科
- 南京建国医院
- 南通广济男科
- 济南博肤胎记医院
- 长沙博肤胎记医院
- 临汾尧都丰华医院
- 长沙和谐医院性病科
- 广州科大中医医院性病科
- 东莞莞医医院性病科
- 永州东方医院
- 无锡建国中医院
- 重庆天佑儿童医院
- 温州广慈医院
- 福州泌尿专科医院
- 泉州新阳光医院
- 昆明男健医院
- 河北蕴育中西医结合医院
- 广州大医中医医院
- 株洲九龙医院
- 赤峰阳光泌尿专科医院
- 德州世纪男科医院
- 重庆北大阳光医院
- 哈尔滨肤康皮肤病医院
- 广州科大中医医院紫癜
- 杭州华实妇科医院
- 惠州友禾医院
- 无锡东方肛肠医院
- 天津博大甲状腺医院
- 北京卫人医院银屑病专科
- 宁波鄞州博润银屑病专病门诊
- 沈阳中亚银屑病医院
- 南昌第十二医院儿科
- 郑州金水康耀中医门诊部
- 贵阳六一儿童医院
- 盐城馨德肛肠医院
- 平顶山交运男科医院
- 更多医院在线
- 北京预防保健科医院
- 天津预防保健科医院
- 上海预防保健科医院
- 重庆预防保健科医院
- 石家庄预防保健科医院
- 唐山预防保健科医院
- 秦皇岛预防保健科医院
- 邯郸预防保健科医院
- 邢台预防保健科医院
- 保定预防保健科医院
- 张家口预防保健科医院
- 承德预防保健科医院
- 沧州预防保健科医院
- 廊坊预防保健科医院
- 衡水预防保健科医院
- 太原预防保健科医院
- 大同预防保健科医院
- 阳泉预防保健科医院
- 长治预防保健科医院
- 晋城预防保健科医院
- 朔州预防保健科医院
- 晋中预防保健科医院
- 运城预防保健科医院
- 忻州预防保健科医院
- 临汾预防保健科医院
- 吕梁预防保健科医院
- 呼和浩特预防保健科医院
- 包头预防保健科医院
- 乌海预防保健科医院
- 赤峰预防保健科医院
- 通辽预防保健科医院
- 鄂尔多斯预防保健科医院
- 呼伦贝尔预防保健科医院
- 巴彦淖尔预防保健科医院
- 乌兰察布预防保健科医院
- 兴安盟预防保健科医院
- 锡林郭勒盟预防保健科医院
- 阿拉善盟预防保健科医院
- 沈阳预防保健科医院
- 大连预防保健科医院
- 鞍山预防保健科医院
- 抚顺预防保健科医院
- 本溪预防保健科医院
- 丹东预防保健科医院
- 锦州预防保健科医院
- 营口预防保健科医院
- 阜新预防保健科医院
- 辽阳预防保健科医院
- 盘锦预防保健科医院
- 铁岭预防保健科医院
- 朝阳预防保健科医院
- 葫芦岛预防保健科医院
- 长春预防保健科医院
- 吉林预防保健科医院
- 四平预防保健科医院
- 辽源预防保健科医院
- 通化预防保健科医院
- 白山预防保健科医院
- 松原预防保健科医院
- 白城预防保健科医院
- 延边预防保健科医院
- 哈尔滨预防保健科医院
- 齐齐哈尔预防保健科医院
- 鸡西预防保健科医院
- 鹤岗预防保健科医院
- 双鸭山预防保健科医院
- 大庆预防保健科医院
- 伊春预防保健科医院
- 佳木斯预防保健科医院
- 七台河预防保健科医院
- 牡丹江预防保健科医院
- 黑河预防保健科医院
- 绥化预防保健科医院
- 大兴安岭预防保健科医院
- 南京预防保健科医院
- 无锡预防保健科医院
- 徐州预防保健科医院
- 常州预防保健科医院
- 苏州预防保健科医院
- 南通预防保健科医院
- 连云港预防保健科医院
- 淮安预防保健科医院
- 盐城预防保健科医院
- 扬州预防保健科医院
- 镇江预防保健科医院
- 泰州预防保健科医院
- 宿迁预防保健科医院
- 杭州预防保健科医院
- 宁波预防保健科医院
- 温州预防保健科医院
- 嘉兴预防保健科医院
- 湖州预防保健科医院
- 绍兴预防保健科医院
- 金华预防保健科医院
- 衢州预防保健科医院
- 舟山预防保健科医院
- 台州预防保健科医院
- 丽水预防保健科医院
- 合肥预防保健科医院
- 芜湖预防保健科医院
- 蚌埠预防保健科医院
- 淮南预防保健科医院
- 马鞍山预防保健科医院
- 淮北预防保健科医院
- 铜陵预防保健科医院
- 安庆预防保健科医院
- 黄山预防保健科医院
- 滁州预防保健科医院
- 阜阳预防保健科医院
- 宿州预防保健科医院
- 六安预防保健科医院
- 亳州预防保健科医院
- 池州预防保健科医院
- 宣城预防保健科医院
- 福州预防保健科医院
- 厦门预防保健科医院
- 莆田预防保健科医院
- 三明预防保健科医院
- 泉州预防保健科医院
- 漳州预防保健科医院
- 南平预防保健科医院
- 龙岩预防保健科医院
- 宁德预防保健科医院
- 南昌预防保健科医院
- 景德镇预防保健科医院
- 萍乡预防保健科医院
- 九江预防保健科医院
- 新余预防保健科医院
- 鹰潭预防保健科医院
- 赣州预防保健科医院
- 吉安预防保健科医院
- 宜春预防保健科医院
- 抚州预防保健科医院
- 上饶预防保健科医院
- 济南预防保健科医院
- 青岛预防保健科医院
- 淄博预防保健科医院
- 枣庄预防保健科医院
- 东营预防保健科医院
- 烟台预防保健科医院
- 潍坊预防保健科医院
- 济宁预防保健科医院
- 泰安预防保健科医院
- 威海预防保健科医院
- 日照预防保健科医院
- 莱芜预防保健科医院
- 临沂预防保健科医院
- 德州预防保健科医院
- 聊城预防保健科医院
- 滨州预防保健科医院
- 菏泽预防保健科医院
- 郑州预防保健科医院
- 开封预防保健科医院
- 洛阳预防保健科医院
- 平顶山预防保健科医院
- 安阳预防保健科医院
- 鹤壁预防保健科医院
- 新乡预防保健科医院
- 焦作预防保健科医院
- 濮阳预防保健科医院
- 许昌预防保健科医院
- 漯河预防保健科医院
- 三门峡预防保健科医院
- 南阳预防保健科医院
- 商丘预防保健科医院
- 信阳预防保健科医院
- 周口预防保健科医院
- 驻马店预防保健科医院
- 武汉预防保健科医院
- 黄石预防保健科医院
- 十堰预防保健科医院
- 宜昌预防保健科医院
- 襄阳预防保健科医院
- 鄂州预防保健科医院
- 荆门预防保健科医院
- 孝感预防保健科医院
- 荆州预防保健科医院
- 黄冈预防保健科医院
- 咸宁预防保健科医院
- 随州预防保健科医院
- 恩施预防保健科医院
- 长沙预防保健科医院
- 株洲预防保健科医院
- 湘潭预防保健科医院
- 衡阳预防保健科医院
- 邵阳预防保健科医院
- 岳阳预防保健科医院
- 常德预防保健科医院
- 张家界预防保健科医院
- 益阳预防保健科医院
- 郴州预防保健科医院
- 永州预防保健科医院
- 怀化预防保健科医院
- 娄底预防保健科医院
- 湘西预防保健科医院
- 广州预防保健科医院
- 韶关预防保健科医院
- 深圳预防保健科医院
- 珠海预防保健科医院
- 汕头预防保健科医院
- 佛山预防保健科医院
- 江门预防保健科医院
- 湛江预防保健科医院
- 茂名预防保健科医院
- 肇庆预防保健科医院
- 惠州预防保健科医院
- 梅州预防保健科医院
- 汕尾预防保健科医院
- 河源预防保健科医院
- 阳江预防保健科医院
- 清远预防保健科医院
- 东莞预防保健科医院
- 中山预防保健科医院
- 潮州预防保健科医院
- 揭阳预防保健科医院
- 云浮预防保健科医院
- 南宁预防保健科医院
- 柳州预防保健科医院
- 桂林预防保健科医院
- 梧州预防保健科医院
- 北海预防保健科医院
- 防城港预防保健科医院
- 钦州预防保健科医院
- 贵港预防保健科医院
- 玉林预防保健科医院
- 百色预防保健科医院
- 贺州预防保健科医院
- 河池预防保健科医院
- 来宾预防保健科医院
- 崇左预防保健科医院
- 海口预防保健科医院
- 三亚预防保健科医院
- 成都预防保健科医院
- 自贡预防保健科医院
- 攀枝花预防保健科医院
- 泸州预防保健科医院
- 德阳预防保健科医院
- 绵阳预防保健科医院
- 广元预防保健科医院
- 遂宁预防保健科医院
- 内江预防保健科医院
- 乐山预防保健科医院
- 南充预防保健科医院
- 眉山预防保健科医院
- 宜宾预防保健科医院
- 广安预防保健科医院
- 达州预防保健科医院
- 雅安预防保健科医院
- 巴中预防保健科医院
- 资阳预防保健科医院
- 阿坝预防保健科医院
- 甘孜预防保健科医院
- 凉山预防保健科医院
- 贵阳预防保健科医院
- 六盘水预防保健科医院
- 遵义预防保健科医院
- 安顺预防保健科医院
- 铜仁预防保健科医院
- 黔西预防保健科医院
- 毕节预防保健科医院
- 黔东预防保健科医院
- 黔南预防保健科医院
- 昆明预防保健科医院
- 曲靖预防保健科医院
- 玉溪预防保健科医院
- 保山预防保健科医院
- 昭通预防保健科医院
- 丽江预防保健科医院
- 普洱预防保健科医院
- 临沧预防保健科医院
- 楚雄预防保健科医院
- 红河预防保健科医院
- 文山预防保健科医院
- 西双版纳预防保健科医院
- 大理预防保健科医院
- 德宏预防保健科医院
- 怒江预防保健科医院
- 迪庆州预防保健科医院
- 拉萨预防保健科医院
- 昌都预防保健科医院
- 山南预防保健科医院
- 日喀则预防保健科医院
- 那曲预防保健科医院
- 阿里预防保健科医院
- 林芝预防保健科医院
- 西安预防保健科医院
- 铜川预防保健科医院
- 宝鸡预防保健科医院
- 咸阳预防保健科医院
- 渭南预防保健科医院
- 延安预防保健科医院
- 汉中预防保健科医院
- 榆林预防保健科医院
- 安康预防保健科医院
- 商洛预防保健科医院
- 兰州预防保健科医院
- 嘉峪关预防保健科医院
- 金昌预防保健科医院
- 白银预防保健科医院
- 天水预防保健科医院
- 武威预防保健科医院
- 张掖预防保健科医院
- 平凉预防保健科医院
- 酒泉预防保健科医院
- 庆阳预防保健科医院
- 定西预防保健科医院
- 陇南预防保健科医院
- 临夏预防保健科医院
- 甘南预防保健科医院
- 西宁预防保健科医院
- 海东预防保健科医院
- 海北预防保健科医院
- 黄南预防保健科医院
- 海南预防保健科医院
- 果洛预防保健科医院
- 玉树预防保健科医院
- 海西预防保健科医院
- 银川预防保健科医院
- 石嘴山预防保健科医院
- 吴忠预防保健科医院
- 固原预防保健科医院
- 中卫预防保健科医院
- 乌鲁木齐预防保健科医院
- 克拉玛依预防保健科医院
- 吐鲁番预防保健科医院
- 哈密预防保健科医院
- 昌吉预防保健科医院
- 博州预防保健科医院
- 巴州预防保健科医院
- 阿克苏预防保健科医院
- 克州预防保健科医院
- 喀什预防保健科医院
- 和田预防保健科医院
- 伊犁预防保健科医院
- 塔城预防保健科医院
- 阿勒泰预防保健科医院
- 台北预防保健科医院
- 新北预防保健科医院
- 台中预防保健科医院
- 台南预防保健科医院
- 高雄预防保健科医院
- 基隆预防保健科医院
- 新竹市预防保健科医院
- 嘉義预防保健科医院
- 宜兰预防保健科医院
- 桃园预防保健科医院
- 新竹县预防保健科医院
- 苗栗预防保健科医院
- 彰化预防保健科医院
- 南投预防保健科医院
- 云林预防保健科医院
- 嘉义预防保健科医院
- 屏东预防保健科医院
- 台东预防保健科医院
- 花莲预防保健科医院
- 澎湖预防保健科医院
- 香港岛预防保健科医院
- 九龙预防保健科医院
- 新界预防保健科医院
- 市辖区预防保健科医院
- 更多专科医院




